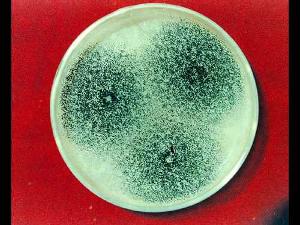
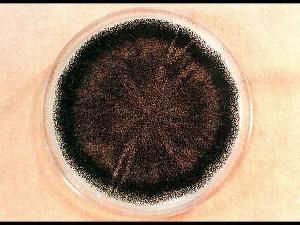

簡介
 黴菌
黴菌黴菌(molds)黴菌是形成分枝菌絲的真菌的統稱。不是分類學的名詞,在分類上屬於真菌門的各個亞門。構成黴菌體的基本單位稱為菌絲,呈長管狀,寬度2~10微米,可不斷自前端生長並分枝。無隔或有隔,具1至多個細胞核。細胞壁分為三層:外層無定形的β葡聚糖(87nm);中層是糖蛋白,蛋白質網中間填充葡聚糖(49nm);內層是幾丁質微纖維,夾雜無定形蛋白質(20nm)。在固體基質上生長時,部分菌絲深入基質吸收養料,稱為基質菌絲或營養菌絲;向空中伸展的稱氣生菌絲,可進一步發育為繁殖菌絲,產生孢子。大量菌絲交織成絨毛狀、絮狀或網狀等,稱為菌絲體。菌絲體常呈白色、褐色、灰色,或呈鮮艷的顏色(菌落為白色毛狀的是毛霉,綠色的為青黴,黃色的為黃麴黴),有的可產生色素使基質著色。黴菌繁殖迅速,常造成食品、用具大量霉腐變質,但許多有益種類已被廣泛套用,是人類實踐活動中最早利用和認識的一類微生物。黴菌是絲狀真菌的俗稱,意即“發霉的真菌”,它們往往能形成分枝繁茂的菌絲體,但又不象蘑菇那樣產生大型的子實體。在潮濕溫暖的地方,很多物品上長出一些。肉眼可見的絨毛狀、絮狀或蛛網狀的菌落,那就是黴菌。其細胞壁主要成分為幾丁質,注意與鏈黴菌(放線菌)區分黴菌菌落的特徵:A、形態較大,質地疏鬆,外觀乾燥,不透明,呈現或松或緊的形狀。B、菌落和培養基間的連線緊密,不易挑取,菌落正面與反面的顏色、構造,以及邊緣與中心的顏色、構造常不一致。C、黴菌的菌絲有營養菌絲和氣生菌絲的分化,而氣生菌絲沒有毛細管水,故它們的菌落必然與細菌或酵母菌的不同,較接近放線菌。黴菌的菌絲。構成黴菌營養體的基本單位是菌絲。菌絲是一種管狀的細絲,把它放在顯微鏡下觀察,很像一根透明膠管,它的直徑一般為3~10微米,比細菌和放線菌的細胞約粗幾倍到幾十倍。菌絲可伸長並產生分枝,許多分枝的菌絲相互交織在一起,就叫菌絲體。根據菌絲中是否存在隔膜,可把黴菌菌絲分成兩種類型:無隔膜菌絲和有隔膜菌絲。無隔膜菌絲中無隔膜,整團菌絲體就是一個單細胞,其中含有多個細胞核。這是低等真菌所具有的菌絲類型。有隔膜菌絲中有隔膜,被隔膜隔開的一段菌絲就是一個細胞,菌絲體由很多個細胞組成,每個細胞內有1個或多個細胞核。在隔膜上有1至多個小孔,使細胞之間的細胞質和營養物質可以相互溝通。這是高等真菌所具有的菌絲類型。為適應不同的環境條件和更有效地攝取營養滿足生長發育的需要,許多黴菌的菌絲可以分化成一些特殊的形態和組織,這種特化的形態稱為菌絲變態。生長在固體培養基上的黴菌菌絲可分為三部分:①營養菌絲:深入的培養基內,吸收營養物質的菌絲;②氣生菌絲:營養菌絲向空中生長的菌絲;③繁殖菌絲:部分氣生菌絲髮育到一定階段,分化為繁殖菌絲,產生孢子。吸器。由專性寄生黴菌如鏽菌、霜黴菌和白粉菌等產生的菌絲變態,它們是從菌絲上產生出來的旁枝,侵入細胞內分化成根狀、指狀、球狀和佛手狀等,用以吸收寄主細胞內的養料。假根。根霉屬黴菌的菌絲與營養基質接觸處分化出的根狀結構,有固著和吸收養料的功能。菌網和菌環。某些捕食性黴菌的菌絲變態成環狀或網狀,用於捕捉其它小生物如線蟲、草履蟲等。菌核。大量菌絲集聚成的緊密組織,是一種休眠體,可抵抗不良的環境條件。其外層組織堅硬,顏色較深;內層疏鬆,大多呈白色。如藥用的茯苓、麥角都是菌核。子實體。是由大量氣生菌絲體特化而成,子實體是指在裡面或上面可產生孢子的、有一定形狀的任何構造。例如有三類能產有性孢子的結構複雜的子實體,分別稱為閉囊殼、子囊殼和子囊盤。黴菌有著極強的繁殖能力,而且繁殖方式也是多種多樣的。雖然黴菌菌絲體上任一片段在適宜條件下都能發展成新個體,但在自然界中,黴菌主要依靠產生形形色色的無性或有性孢子進行繁殖。孢子有點像植物的種子,不過數量特別多,特別小。黴菌的無性孢子直接由生殖菌絲的分化而形成,常見的有節孢子、厚垣孢子、孢囊孢子和分生孢子。黴菌的孢子具有小、輕、乾、多,以及形態色澤各異、休眠期長和抗逆性強等特點,每個個體所產生的孢子數,經常是成千上萬的,有時竟達幾百億、幾千億甚至更多。這些特點有助於黴菌在自然界中隨處散播和繁殖。對人類的實踐來說,孢子的這些特點有利於接種、擴大培養、菌種選育、保藏和鑑定等工作,對人類的不利之處則是易於造成污染、霉變和易於傳播動植物的黴菌病害。由於黴菌的菌絲較粗而長,因而黴菌的菌落較大,有的黴菌的菌絲蔓延,沒有局限性,其菌落可擴展到整個培養皿,有的種則有一定的局限性,直徑1~2厘米或更小。菌落質地一般比放線菌疏鬆,外觀乾燥,不透明,呈現或緊或松的蛛網狀、絨毛狀或棉絮狀;菌落與培養基的連線緊密,不易挑取;菌落正反面的顏色和邊緣與中心的顏色常不一致。
預防方法
黴菌在我們的生活中無處不在,他比較青睞於溫暖潮濕的環境,一有合適的環境就會大量的繁殖,必須採取措施來阻止黴菌的繁殖或切斷其傳播途徑,就可以擺脫黴菌的感染:
人體預防
黴菌
黴菌1.注意身體某部位黴菌的滋生,比如指甲,有時黴菌會侵入指甲造成灰指甲,所以指甲不要留長,經常清理。多汗的皮膚褶皺里,特別是胖人皮膚褶皺比較多,如果是夏季出汗多,有可能在褶皺處滋生黴菌。還有就是腳部也是黴菌滋生的有利環境,有腳氣的人就更應該注意,防止引起其他部位感染。
2.自己的內褲要單獨洗,特別是家人或自己有足癬或灰指甲時更應該注意,為了防止交叉感染都應該分開來洗。
3.不要濫用抗生素,大量吃抗生素可能會將有益人體健康的菌群給抑制住,破壞人體的天然防禦屏障,造成黴菌的的大量繁殖。
4.警惕洗衣機中隱藏黴菌,洗衣機用的久了肯定會滋生黴菌,最簡單的方法就是用60度左右的水來徹底清洗就行了。同時洗完的衣物一定要在太陽下晾曬,陽光中的紫外線可以殺死殘存的黴菌。
5.在公共場所最好不要用公用的或者別人用過的洗具。同時選用適宜的個人清潔護理產品。
6.正確的避孕,避孕藥中的雌激素有促進黴菌侵襲的作用。如果反覆發生黴菌性陰道炎,就儘量不要使用藥物避孕。
7.內褲最好選擇棉質的,緊身化纖內褲會使陰道局部的溫度及濕度增高,有利於黴菌生長。
8.如果患有黴菌性陰道炎,自己治療的同時,男方也應同時接受治療,避免交叉感染。
9.穿著全棉內褲。緊身化纖內褲會使陰道局部的溫度及濕度增高,這可是黴菌拍手稱快的“居住”環境!還是選用棉質的內褲吧!
10.控制血糖,鹼性產品清洗外陰.女性糖尿病人陰道糖原含量和酸度偏高,易於被黴菌侵害。所以,在控制血糖的同時,還要注意清洗外陰,選用pH值弱鹼性產品。
食物預防
1.土法防霉在100公斤的大米中放1公斤海帶,可有效殺滅害蟲、抑制黴菌。雖然防霉變的方法很多,但要消除黴菌毒素的危害是有限的,因此對一些已霉變的食品,不要吝惜,一定要及時丟掉,千萬不要持僥倖心理食用,否則會引起食物中毒。
2.低氧保藏防霉黴菌多屬於需氧微生物,生長繁殖需要氧氣,所以瓶(罐)裝食品在滅菌後,充以氮氣或二氧化碳,加入脫氧劑、將食物夯實,進行脫氣處理或加入油封等,都可以造成缺氧環境,防止大多數黴菌繁殖。例如:
●醬油:在裝醬油的瓶子裡滴一層熟豆油或麻油,讓醬油與空氣隔絕,可防止黴菌繁殖生長。
●香腸、肉類醃製食品:用棉簽蘸上少許菜油或香油,均勻地塗抹在其表面,即可防霉變。
●醋:醋瓶內加入少許芝麻油或熟花生油,使醋與空氣隔絕,防止長白膜。
●乾香茹、木耳、筍乾、蝦米等乾貨置密封的容器內保存。
3.食物放置在通風、乾燥的環境中較好。
4.低溫防霉肉類食品,在0℃的低溫下,可以保存20天不變;年糕完全浸泡在裝有水的瓷缸內,水溫保持在10℃以下,即可防霉變。
5.加熱殺菌法對於大多數黴菌,加熱至80℃,持續20分鐘即可殺滅;黴菌抗射線能力較弱,可用放射性同位素放出的射線殺滅黴菌。但黃麴黴毒素耐高溫,巴氏消毒(80℃)都不能破壞其毒性。
6.收割後的糧食要及時晾曬、烘乾,儲存在通風、乾燥的環境中。在農村地區,如發現儲藏的糧食中只有少量霉變,可以採取下面的方法:發霉的玉米、花生等大粒穀物,可用人工方法把發霉的玉米粒、花生粒挑掉;發霉的麥子、大米等小粒穀物可用漂洗的方法將霉粒漂洗掉。
飼料預防
 黴菌
黴菌1.選用和培育抗菌的飼料作物品種。不同的飼料作物品種對黴菌的敏感性不同,因此培育抗菌性品種,可使飼料作物受黴菌侵染的幾率大幅度下降。這也是防霉的根本途徑,而生物基因工程逐步擴大套用,使培育抗性品種切實可行。
2.選擇適當的種植或收穫技術。試驗結果表明,從花生分離到的黃麴黴有80%—90%能產生毒素,遠遠高於從其他作物分離到的黃麴黴。所以在連續種植花生的田塊里的花生,黃麴黴污染率高,黃麴黴毒素(AF)的含量也高,破碎的花生易污染黃麴黴,也有利於毒素的生成,故如果採取輪作等種植技術和適當的收穫方法將可大降低黴菌和黴菌毒素的污染。另外,收穫和儲運過程中應儘量避免蟲咬、鼠啃、、磨壓,避免玉米、花生等穀物的表皮和外殼損傷;破碎的籽粒應除去,因為這樣的籽粒往往被高度污染。
3.嚴格控制飼料和原料的水分含量。引起飼料霉變的三個主要條件是濕度、溫度和氧氣。如果我們能控制這三個條件之一,即可有效地防止霉變。一般情況下,把水分控制在安全線以下是最簡便易行的方法,故作物收穫後應迅速將其乾燥,且必須保證乾燥均勻一致。稻穀中的水分宜控制在13%以下,玉米在21.5%以下,花生在8%以下。
4.改善貯藏條件,抑制黴菌生長。飼料霉變大部分是在貯藏過程中發生的,因此貯藏過程中的防霉是飼料防霉的重要環節。
4.1物理防霉法:主要有控制貯藏環境的溫度、封閉隔氧貯存、氣調貯藏、低溫通風貯藏以及輻射法等。據介紹,將脫粒後的濕玉米裝入內襯塑膠袋的麻袋,儘量裝滿並紮緊袋口,此後因為玉米本身的呼吸作用,消耗了袋中的氧,不僅黃麴黴難以生長,其他黴菌也可受到抑制,是經濟簡便、很有前途的防霉方法。國內常用低溫通風貯藏法,採取低溫與機械通風相結合,使飼料達到安全水分含量。不僅適用於顆粒飼料,而且對水分含量較高的粉料套用效果也較明顯。隨著輻射食品技術的發展,套用輻射處理飼料的研究和套用也在不少國家發展起來。?
4.2化學防霉法添加防霉劑:此法比較適合飼料工業。作為飼料防霉劑必須既有抑制黴菌作用,又要對人畜無害且價廉,使用方便、可靠。常被用作防霉劑的有丙酸及其鹽類、山梨酸及其鹽類、雙乙酸鈉、乙氧喹、延胡索酸、胱氫醋酸鹽、龍膽紫、富馬酸二甲酯等。世界飼料工業用防霉劑耗量大的是丙酸及其鹽類,其次是山梨酸及其鹽類乙酸。利處理:乙酸利的主要作用是抑制AF的生物合成。將乙烯利酸配成9%—15%的水溶液,取其相當新鮮花生量35%的液重,與花生充分攪拌混合,於28—30攝氏度、相對濕度100%的環境中貯存於聚乙袋中,90日內仍無AF的生物合成。
4.3微生物抑制法:日本永森食品公司發現7種能吞噬黃麴黴和抑制AF產生的微生物,但尚未見到實用的報導。
4.4綜合法:酶和抗氧化劑作為防霉劑,是近幾年來國際上出現的新型高效防霉劑。它的作用原理與化學防霉劑的防霉原理不同,它是以外加酶取代黴菌體內的酶系,並以抗氧化劑阻礙黴菌正常的氧氣吸收,從而阻礙黴菌正常的生理功能達到防霉效果。所使用的酶,要較黴菌體內的酶強1—500倍,作用於黴菌時,菌體內的酶就遭到破壞,發生變性,使黴菌不能從飼料中吸取營養,再加上抗氧化劑的作用,黴菌得不到充足的氧氣,從而抑制其生長。這種防霉劑對黴菌來說不會產生抗性,而且使用安全可靠,對外界無不良影響。
黴菌試驗就是檢測產品抗黴菌的能力和在有利於黴菌生長的條件下(即高濕溫暖的環境中和有無機鹽存在的條件下),設備是否受到黴菌的有害影響。
黴菌試驗的標準主要有:
GJB 150.10-1986軍用設備環境試驗方法黴菌試驗。
HB 6167.11-1989民用飛機機載設備環境條件和試驗方法黴菌試驗。
GJB4.10 艦船電子設備環境試驗黴菌試驗。
GB T 2423.16-1999 電工電子產品環境試驗第2部分試驗方法 試驗J和導則長霉。
GB/T10588-2002 GB 10588-89
能進行黴菌試驗的實驗室很少,知道的就環境可靠性與電磁兼容試驗中心、某空軍研究所等。
環境影響
一、針對於外部環境黴菌易產生地方和原因
黴菌
黴菌1.生產車間牆壁潮濕,在潮濕部位容易生長黴菌。
2.車間存在冷凝水的管路、牆壁等容易生長黴菌,水管的破裂,也會導致黴菌的產生。
3.空氣中總是包含一定水蒸氣,只不過大部分情況下我們看不到,不過,當水蒸氣液化的時候,比如當我們沐浴或是泡澡的時候,浴室內鏡子的表面就會變得潮濕,這時候我們就能夠看到他們。熱空氣中包含很多的水分,當熱空氣冷卻時,水分就會冷凝、液化。冷凝、液化通常是發生在房屋中溫度最低的部位,比如牆壁上溫度低的部位,正是在這些溫度低的部位,最容易產生黴菌。
4.車間裡無法保證正常的換氣,無法讓車間保證在規定濕度情況下,容易生長黴菌。
5.車間忽冷忽熱,容易產生冷凝水的地方,容易糟到黴菌侵害。
6.離牆近的設備容易產生冷凝水,容易產生黴菌。
7.溫度相對較低的車間的門,請一直保持關閉狀態。如果這些溫度較低車間的門沒有關閉的話,那么旁邊車間傳過來的熱空氣湧進行,就形成很高的濕度,從而在空氣冷卻的時候形成液化,容易生長黴菌。
8.保證空調的正常運轉,保證車間內部空氣能夠達到要求指標,空調的換氣程度好壞直接影響到黴菌的產生。如果車間能保證及時將含有大量水份的空氣排出車間,則極大程度縮小了可能存在黴菌的可能性。
二、黴菌一旦進入食品,
影響黴菌生長繁殖及產毒的因素是很多的,與食品關係密切的有水份、溫度、基質、通風等條件,為此,控制這些條件,可以對食品中黴菌分布及產毒造成很大的影響。
1.水份
黴菌生長繁殖主要的條件之一是必須保持一定的水份,一般來說,米麥類水份在14%以下,大豆類在11%以下,乾菜和乾果品在30%以下,微生物是較難生長的。食品中真正能被微生物利用的那部分水份又稱為水份活性(Wateractivity縮寫為Aw),Aw越接近於1,微生物最易生長繁殖。食品中的Aw為0.98時。微生物最易生長繁殖,當Aw降為0.93以下時,微生物繁殖受到抑制,但黴菌仍能生長,當Aw在0.7以下時,則黴菌的繁殖受到抑制,可以阻止產毒的黴菌繁殖。
2.溫度
溫度對黴菌的繁殖及產毒均有重要的影響,不同種類的黴菌其最適溫度是不一樣的,大多數黴菌繁殖最適宜的溫度為25~30℃,在0℃以下或30℃以上,不能產毒或產毒力減弱。如黃麴黴的最低繁殖溫度範圍是6-8℃,最高繁殖溫度是44~46℃,最適生長溫度37℃左右。但產毒溫度則不一樣,略低於生長最適溫度,如黃麴黴的最適產毒溫度為28-32℃。
3.食品基質
與其它微生物生長繁殖的條件一樣,不同的食品基質黴菌生長的情況是不同的,一般而言,營養豐富的食品其黴菌生長的可能性就大,天然基質比人工培養基產毒為好。實驗證實,同一黴菌菌株在同樣培養條件下,以富於糖類的小麥、米為基質比油料為基質的黃麴黴毒素產毒量高。另外,緩慢通風較快速風乾黴菌容易繁殖產毒。
4.黴菌種類
不同種類的黴菌其生長繁殖的速度和產毒的能力是有差異黴菌毒素中毒性最強者有黃麴黴毒素、赭麴黴毒素、黃綠青黴素、紅色青黴素及青黴酸。已知有五種毒素可引起動物致癌,它們是典麴黴毒素(B?1、G?1、M?1)、黃天精、環氯素、雜色麴黴素和展青黴素
對付黴菌
黴菌能夠引發過敏性鼻炎,黴菌隱藏在潮濕的地方,如:浴室、衛生間、櫥櫃、水池附近。大量黴菌會引發支氣管哮喘,為避免家中出現黴菌,要做到:
經常使用活性炭,以保持家中乾燥。
清空家裡的罈罈罐罐,防止發生霉變。
衛生間和浴室等封閉空間要經常通風。
檢查水龍頭、水管,防止漏水。
主要危害
黴菌毒素對人和畜禽主要毒性表現在神經和內分泌紊亂、免疫抑制、致癌致畸、肝腎損傷、繁殖障礙等。雞天生對黴菌毒素敏感,飼料中較低的毒素含量就會造成雞群大量死亡。黴菌毒素對蛋雞的影響集中表現在:卵巢和輸卵管萎縮,產蛋量下降,產畸形蛋;採食量減少、生產性能下降、飼料報酬降低;種蛋的孵化率降低。不同黴菌毒素對蛋雞造成的危害有所區別。在已經知道的黴菌毒素中對蛋雞影響及毒害作用較大的有麥角毒素、單端孢黴毒素、腐馬毒素、玉米赤霉烯酮、黃麴黴毒素、赭麴黴毒素等。
麥角毒素
麥角毒素是由穀物中的麥角屬真菌分泌,化學本質是菌核內的眾多生物鹼組成的化學基團。在這些化學基團中,有的生物鹼侵害神經系統,引起痙攣和感覺神經紊亂;有的侵害血管系統,引起血管收縮和肢體壞疽;有的侵害內分泌系統,影響垂體前葉神經內分,泌的調控。因此,麥角中毒以血管、神經和內分泌紊亂為特徵,產蛋雞麥角中毒表現為飼料採食量減少,產蛋率下降,排稀糞等。
 發霉食物
發霉食物單端孢黴毒素
包括鐮刀菌屬在內的多屬黴菌均可產生各種單端孢黴毒素,研究表明,在發現的100多種單端孢黴毒素中約一半是由鐮刀菌屬產生。作用機理是破壞結構性脂質,抑制蛋白合成和DNA合成。蛋雞採食該類毒素污染的飼料後幾天時間內,產蛋量迅速下降,蛋殼變薄,病雞口腔黏膜潰爛形成黃色疥痂,剖檢可見肝呈棕黃色,易碎,腎臟腫脹,輸卵管內尿酸鹽沉積,嗉囊有局部潰瘍,肌胃壁增厚。
腐馬毒素
由串珠鐮刀菌分泌,中毒的機理是破壞鞘脂類的合成。蛋雞的中毒症狀表現為拉稀、排黑色粘性糞便,採食減少 體重減輕、肢體殘廢,死亡率增加。體外實驗證明,腐馬毒素對巨噬細胞和淋巴細胞有毒性作用,降低免疫細胞的殺菌活性。
玉米赤霉烯酮
玉米赤霉烯酮主要由禾穀鐮刀菌產生,粉紅鐮刀菌、三線鐮刀菌等多種鐮刀菌也能產生這種毒素。玉米赤霉烯酮是一種取代的2,4—二羥基苯甲酸內酯,有包括玉米赤霉醇在內的七種衍生物,是一種對雞毒性很強的植物性雌激素。蛋雞中毒的臨床表現為雞冠腫大、卵巢萎縮、產蛋率下降,有的出現腹水症。
黃麴黴毒素
黃麴黴毒素是高毒性和高致癌性毒素,由黃麴黴菌、寄生麴黴和軟毛青黴產生。黃麴黴毒素是由兩個不等的二氫呋喃妥因環組成的化合物。它與細胞核和線粒體DNA結合,造成蛋白質合成受損,干擾肝腎功能,抑制免疫系統。蛋雞臨床表現為食欲不振、產蛋率下降、死亡率提高。剖檢可見肝腎腫大蒼白、皮下出血、心包積水、膽囊擴張、卡他性腸炎;鏡檢可見肝臟脂肪變性、膽管增生。
赭麴黴毒素
赭麴黴毒素是由赭麴黴和純綠青黴產生的一種腎毒素,是對家禽最毒的黴菌毒素。赭麴黴毒素中毒可以引起原發性腎病,也可影響肝臟、免疫器官和造血功能。剖檢可見肝臟、胰臟、腎臟蒼白,腎臟腫脹,輸尿管有白色尿酸鹽沉積。污染赭麴黴毒素的飼料適口性差,蛋雞會因厭食而體重下降,產蛋量和品質下降。對種蛋,赭麴黴毒素中毒會造成畸形胚增加。
防治對策
1加強飼料生產的管理首先要嚴把原料採購關,杜絕霉變原料入庫;控制倉庫的溫度濕度,注意通風,做好對倉庫邊角清理工作,防止原料在儲存過程中變質;控制飼料加工、配製、運輸等環節,控制飼料的儲存環境,儘量縮短儲存時間,防止飼料在禽舍中發霉變質。 2合理使用飼料防霉劑飼料防霉劑,要具備抑制黴菌生長,但又對動物無毒的特點。因此,作為飼料防霉劑,必須符合以下三個原則:一是具有較強的廣譜抑菌效果;二是pH值低,在低水分的飼料中能釋放出來;三是操作方便,使用安全、經濟、無致癌、致畸、致突變作用,有效添加量不影響動物健康及飼料的適口性。目前,常用的防霉劑主要有以下三大類:第一類為有機酸,如丙酸、山梨酸、苯甲酸、乙酸、脫氫醋酸和富馬酸等;第二類為有機酸鹽及其酯,如丙酸鹽、山梨酸鈉(鉀)、苯甲酸鈉和富馬酸二甲酯等;第三類為複合防霉劑。有機酸防霉效果較好、但腐蝕性較大;有機酸鹽防霉效果較有機酸差,且必須在有一定的水分和pH值的條件下才能進行,但腐蝕性小;複合防霉劑防霉效果作用強、腐蝕性小。3中毒蛋雞的治療更換飼料無疑是最有效解決黴菌中毒的方法,在提供無污染的飼料後再使用一定量的黴毒清或制黴菌素,大多數黴菌毒素中毒的家禽很快會恢復健康。此外,補充維生素,例如維生素E和維生素C可以部分抑制T-2毒素和赭曲毒素對蛋雞的毒害;N-乙醯半胱氨酸和硫胺能降低黃麴黴毒素的毒性,其機理是增加了谷光苷肽的合成。
盤點真菌微生物系列(十一)
| 真菌(fungus;eumycetes)是具有真核和細胞壁的異養生物。種屬很多,已報導的屬達1萬以上,種超過10萬個。其營養體除少數低等類型為單細胞外,大多是由纖細管狀菌絲構成的菌絲體。本期為第十一期。 |

